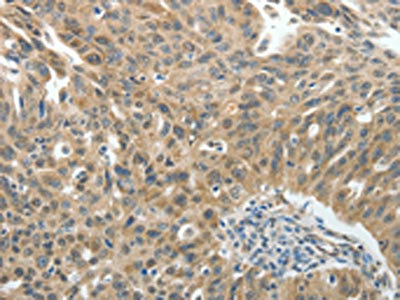

ROCK2 Antibody
-
中文名稱:ROCK2兔多克隆抗體
-
貨號:CSB-PA081497
-
規格:¥1100
-
圖片:
-
The image on the left is immunohistochemistry of paraffin-embedded Human liver cancer tissue using CSB-PA081497(ROCK2 Antibody) at dilution 1/20, on the right is treated with fusion protein. (Original magnification: ×200)
-
The image on the left is immunohistochemistry of paraffin-embedded Human ovarian cancer tissue using CSB-PA081497(ROCK2 Antibody) at dilution 1/20, on the right is treated with fusion protein. (Original magnification: ×200)
-
Gel: 10%SDS-PAGE, Lysate: 40 μg, Lane: Mouse brain tissue, Primary antibody: CSB-PA081497(ROCK2 Antibody) at dilution 1/400, Secondary antibody: Goat anti rabbit IgG at 1/8000 dilution, Exposure time: 1 minute
-
-
其他:
產品詳情
-
Uniprot No.:
-
基因名:
-
別名:coiled-coil-containing protein kinase 2 antibody; KIAA0619 antibody; p164 ROCK 2 antibody; p164 ROCK-2 antibody; Rho associated coiled coil containing protein kinase 2 antibody; Rho associated protein kinase 2 antibody; Rho associated; coiled coil containing protein kinase II antibody; Rho kinase 2 antibody; Rho-associated antibody; Rho-associated protein kinase 2 antibody; ROCK 2 antibody; Rock II antibody; Rock2 antibody; ROCK2_HUMAN antibody; Rock2m antibody; ROK alpha antibody; ROKalpha antibody
-
宿主:Rabbit
-
反應種屬:Human,Mouse,Rat
-
免疫原:Fusion protein of Human ROCK2
-
免疫原種屬:Homo sapiens (Human)
-
標記方式:Non-conjugated
-
抗體亞型:IgG
-
純化方式:Antigen affinity purification
-
濃度:It differs from different batches. Please contact us to confirm it.
-
保存緩沖液:-20°C, pH7.4 PBS, 0.05% NaN3, 40% Glycerol
-
產品提供形式:Liquid
-
應用范圍:ELISA,WB,IHC
-
推薦稀釋比:
Application Recommended Dilution ELISA 1:1000-1:2000 WB 1:200-1:1000 IHC 1:25-1:100 -
Protocols:
-
儲存條件:Upon receipt, store at -20°C or -80°C. Avoid repeated freeze.
-
貨期:Basically, we can dispatch the products out in 1-3 working days after receiving your orders. Delivery time maybe differs from different purchasing way or location, please kindly consult your local distributors for specific delivery time.
-
用途:For Research Use Only. Not for use in diagnostic or therapeutic procedures.
相關產品
靶點詳情
-
功能:Protein kinase which is a key regulator of actin cytoskeleton and cell polarity. Involved in regulation of smooth muscle contraction, actin cytoskeleton organization, stress fiber and focal adhesion formation, neurite retraction, cell adhesion and motility via phosphorylation of ADD1, BRCA2, CNN1, EZR, DPYSL2, EP300, MSN, MYL9/MLC2, NPM1, RDX, PPP1R12A and VIM. Phosphorylates SORL1 and IRF4. Acts as a negative regulator of VEGF-induced angiogenic endothelial cell activation. Positively regulates the activation of p42/MAPK1-p44/MAPK3 and of p90RSK/RPS6KA1 during myogenic differentiation. Plays an important role in the timely initiation of centrosome duplication. Inhibits keratinocyte terminal differentiation. May regulate closure of the eyelids and ventral body wall through organization of actomyosin bundles. Plays a critical role in the regulation of spine and synaptic properties in the hippocampus. Plays an important role in generating the circadian rhythm of the aortic myofilament Ca(2+) sensitivity and vascular contractility by modulating the myosin light chain phosphorylation.
-
基因功能參考文獻:
- ROCK2 is a target of miR-455-3p. PMID: 29932921
- miR130a is a regulator of ROCK2 and can inhibit proliferation, migration and invasive ability of hepatocellular carcinoma cells, at least in part, by suppressing the expression of ROCK2. PMID: 30015839
- Upregulation of ROCK2 was associated with the progression of breast cancer. PMID: 29990315
- ROCK2 participates in cell adhesion by regulating ICAM-1 expression and the co-localization of adhesion molecules with vimentin. PMID: 30165352
- qPCR demonstrated that melatonin downregulated ROCK2 gene expression, and upregulated the expression of the ZO1 and occludin genes. The levels of ZO1 and occludin localized in the tight junctions were markedly increased in the immunofluorescence assay. PMID: 29152648
- This study showed that ROCK2 expression significantly increased in clinical gastric cancer tissues compared with adjacent non-cancer tissues. PMID: 27921230
- The findings indicate that upregulation of the RhoA/ROCK pathway is significantly associated with cardiac hypertrophy-related Ca2+ dysregulation and suggest that ROCK inhibition prevents hypertrophic heart failure. PMID: 29029794
- RhoA is activated in tumors from neuroblastoma patients, and elevated expression of Rho-associated kinase (ROCK)2 is associated with poor patient survival. Pharmacological or genetic inhibition of ROCK1 and 2, key molecules in Rho signaling, resulted in neuroblastoma cell differentiation and inhibition of neuroblastoma cell growth, migration, and invasion. PMID: 28739902
- ROCK1 and ROCK2 contribute to the genetic susceptibility of hypertension and stroke. PMID: 29246448
- these data indicate that ROCK proteins are overexpressed in diverse vascular tumors and suggest that specific targeting of ROCK2 proteins may show efficacy against malignant vascular tumors. PMID: 28709411
- Fasudil exhibited protective effects on smoke exposure induced cognitive deficits which might involve with the regulation of Rho/ROCK/NF-kappaB pathways. PMID: 27791202
- The increase in protein expression of ROCK2 in astrocytes and microglia suggests an important role for ROCK2 in glial Parkinson disease pathology, which is initiated already in normal aging. PMID: 26748453
- ROCK2 protein level was inversely correlated with miR-101 level in NSCLC tissue samples. PMID: 27229528
- RhoE and ROCK2 regulate chemoresistance in hepatocellular carcinoma. PMID: 27213590
- Combined EGFR and ROCK inhibition effectively blocks proliferation of triple-negative breast cancer (TNBC) cells. PMID: 27374095
- Inhibition of ROCK signaling restored polarity, decreased disorganization of F-actin, and led to reduction of proliferation of breast cancer cells. PMID: 27203208
- Data indicate that the ROCKII inhibitor H1152 increases insulin secreting cells from hPSCs and improves beta-cell maturation on transplantation in vivo. PMID: 28824164
- Dexamethasone up-regulates ROCK1/2 activity promoting migration, invasion and metastasis of melanoma cells. PMID: 28923399
- these data suggest that ROCK2 signaling plays a critical role in controlling the development of TFH cells induced by autoimmune conditions through reciprocal regulation of STAT3 and STAT5 activation. PMID: 27436361
- Results showed that ROCK1 gene rs2271255 (Lys222Glu), rs35996865, and ROCK2 gene rs726843, rs2290156, rs10178332, rs35768389 (Asp601Val) polymorphisms were significantly associated with respiratory distress syndrome (RDS), and that they could be a risk factor for development of neonatal RDS. PMID: 27269648
- These findings reveal an ancillary role for increased ROCK signaling in pancreatic cancer progression to promote extracellular matrix remodeling that facilitates proliferation and invasive tumor growth. PMID: 28031255
- Despite sharing the catalytic domain with ROCK2, ROCK1 appears to be the dominant kinase essential for junctional integrity and contractile tension at epithelial ZA. PMID: 28035042
- Studies showed that ROCK isoforms, ROCK1 and ROCK2, have been found in various types of neuron-like cell lines and neurons, and function as different regulators in axon outgrowth, neurite retraction, cell survival, autophagy, energy balance, and generation of endogenous beta amyloid. [review] PMID: 27033194
- These results indicate the differential role of ROCK isoforms in myofibroblast differentiation on soft and stiff matrices. PMID: 28225294
- BCR-ABL-dependent ROCK, but not TK, is involved in CD1d downregulation. We propose that ROCK, which is most likely activated by the DH/PH domain of BCR-ABL, mediates iNKT-cell immune subversion in chronic myeloid leukaemia (CML) patients by downregulating CD1d expression on CML mDCs. PMID: 27513300
- this study shows that ulinastatin inhibites the hyperpermeability of vascular endothelial cells induced by TNF-alpha, and that this inhibitory effect may be related to the RhoA/ROCK2 signaling pathway PMID: 28329735
- Taken together, these results suggest that this newly identified Rock2-beta-catenin/TCF4-SCARA5 axis will provide novel insight into the understanding of the regulatory mechanisms of proliferation in human RCC. PMID: 27793664
- Panax notoginseng saponins provide neuroprotective effects in a rat model of cerebral ischemia and SH-SY5Y cells exposed to oxygen/glucose deprivation injury by inhibiting the overexpression of NgR1, RhoA, and ROCK2. PMID: 27288754
- The positive rates of Rock2 protein in normal esophageal epithelium tissue was 12.3% and in esophageal carcinomas tissues was 56.5%. The expression of Rock2 protein was related with vascular invasion and there was no significant difference between the expression of Rock2 protein and ESCC patients' tumor location, differentiation, T stage, and lymph node metastases. PMID: 27628667
- There are 2 isoforms: ROCK1 and ROCK2. They have different functions in different types of cells and tissues. There is growing evidence that ROCKs contribute to the development of cardiovascular diseases, including cardiac fibrosis, hypertrophy, and subsequent heart failure. PMID: 27251065
- a soft extracellular matrix causes downregulation of ROCK2 expression, which drives resistance to chemotherapy by repressing p53 activation. PMID: 28191463
- Data suggest that Rho-associated coiled-coil containing protein kinase (ROCK) inhibitor Y-27632 may be therapeutically useful in tongue squamous cell carcinoma (TSCC). PMID: 26468018
- Significant associations between ROCK1, ROCK2, RhoA and RhoC gene polymorphisms and systemic sclerosis were demonstrated. PMID: 26615410
- ROCK1 and ROCK2 differentially regulate invadopodia activity through separate signaling pathways. PMID: 26826790
- Uniaxial stretch activates JNK1 via RhoA and ROCK pathways in human bladder smooth muscle cells. PMID: 26928204
- Data clearly suggests association of ROCK2 polymorphisms and haplotypes with high altitude essential hypertension in a Ladakhi Indian population. PMID: 26818475
- 17beta-estradiol induces proliferation of uterine smooth muscle cells in endometriosis through hyperactivation of the estrogen receptor-RhoA/ROCK signaling pathway. PMID: 25940707
- no differences in renal interstitial fibrosis or UUOinduced ROCK activity were identified between the ROCK2 heterozygote knockout and WT mice, indicating that the genetic partial disruption of ROCK2 is insufficient for protecting against renal fibrosis. PMID: 26572751
- Study shows that nuclear ROCKII activation signal might contribute to the tumor metastasis in breast cancer. PMID: 26626121
- ROCK activity in MS serum was elevated compared with serum from healthy controls PMID: 26481340
- This is the first study to examine the involvement of ROCK1 and ROCK2 gene variations in the risk of primary open-angle glaucoma development. PMID: 24617500
- Rho Kinase ROCK2 Mediates Acid-Induced NADPH Oxidase NOX5-S Expression in Human Esophageal Adenocarcinoma Cells PMID: 26901778
- ROCK2 forms a dimer, 120 nm in length, with a long coiled-coil tether linking the kinase and membrane-binding domains. PMID: 26620183
- We speculate that the drop of the ROCK-to-MLCK ratio may occur as an attempt to compensate for the increased Rho kinase activity. PMID: 26468005
- This study report that protein levels of the Rho-associated protein kinases (ROCK2) was increased in Progressive Supranuclear Palsy and Corticobasal Degeneration brains. PMID: 26818518
- Esophageal squamous cell carcinoma showed a positive expression of Rock2, which was significantly association with ethnic background. PMID: 26261605
- Results demonstrated that the miR-200b/200c/429 subfamily inhibited HCC cell migration through modulating Rho/ROCK mediated cell cytoskeletal reorganization and cell-substratum adhesion. PMID: 25909223
- miR-144 suppresses OS progression by directly downregulating ROCK1 and ROCK2 expression. PMID: 25912304
- beta-catenin/TCF4 pathway contributed to the effects of Rock2 in CRC cells, and Rock2 stabilized beta-catenin by preventing its ubiquitination and degradation PMID: 26505794
- ROCK2 is pivotal to baseline junctional tension as a novel mechanism by which Rho kinase primes the endothelium for hyperpermeability responses. PMID: 25869521
顯示更多
收起更多
-
亞細胞定位:Cytoplasm. Cell membrane; Peripheral membrane protein. Nucleus. Cytoplasm, cytoskeleton, microtubule organizing center, centrosome.
-
蛋白家族:Protein kinase superfamily, AGC Ser/Thr protein kinase family
-
組織特異性:Expressed in the brain (at protein level).
-
數據庫鏈接:
Most popular with customers
-
-
Phospho-YAP1 (S127) Recombinant Monoclonal Antibody
Applications: ELISA, WB, IHC
Species Reactivity: Human
-
-
-
-
-
-